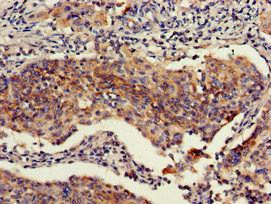

RBBP6 Antibody
-
中文名稱:RBBP6兔多克隆抗體
-
貨號:CSB-PA768776LA01HU
-
規格:¥440
-
圖片:
-
Western Blot
Positive WB detected in: Mouse brain tissue
All lanes: RBBP6 antibody at 2.7μg/ml
Secondary
Goat polyclonal to rabbit IgG at 1/50000 dilution
Predicted band size: 202, 198, 14, 107 kDa
Observed band size: 202 kDa -
Immunohistochemistry of paraffin-embedded human cervical cancer using CSB-PA768776LA01HU at dilution of 1:100
-
Immunohistochemistry of paraffin-embedded human testis tissue using CSB-PA768776LA01HU at dilution of 1:100
-
Immunofluorescent analysis of Hela cells using CSB-PA768776LA01HU at dilution of 1:100 and Alexa Fluor 488-congugated AffiniPure Goat Anti-Rabbit IgG(H+L)
-
-
其他:
產品詳情
-
產品描述:
CUSABIO's product CSB-PA768776LA01HU is a polyclonal antibody against the RBBP6 protein. It is produced in the rabbit immunized with a partial recombinant protein mapping within 51-97 amino acids of the human RBBP6. Its purity reaches up to 95% using protein G purified. This RBBP6 antibody has been validated for use in ELISA, WB, IHC, and IF applications. And it reacts with human and mouse RBBP6 proteins.
RBBP6 protein, also known as p53-dependent damage-inducible nuclear protein 1 (p53DINP1), is a multifunctional protein that plays important roles in various cellular processes, including DNA damage response, transcriptional regulation, and protein quality control. Mutations or dysregulation of RBBP6 can lead to various human diseases, including cancer, neurodegenerative disorders, and metabolic disorders.
-
產品名稱:Rabbit anti-Homo sapiens (Human) RBBP6 Polyclonal antibody
-
Uniprot No.:
-
基因名:RBBP6
-
別名:DKFZp686P0638 antibody; DKFZp761B2423 antibody; E3 ubiquitin-protein ligase RBBP6 antibody; MY038 antibody; P2P R antibody; P2PR antibody; p53 associated cellular protein of testis antibody; p53-associated cellular protein of testis antibody; p53-associated cellular protein, testis-derived antibody; PACT antibody; Proliferation potential related protein antibody; Proliferation potential-related protein antibody; Protein P2P R antibody; Protein P2P-R antibody; Protein P2PR antibody; Protein RBQ 1 antibody; Protein RBQ1 antibody; RB binding protein 6, ubiquitin ligase antibody; RB binding Q protein 1 antibody; RBBP 6 antibody; Rbbp6 antibody; RBBP6_HUMAN antibody; RBQ 1 antibody; RBQ-1 antibody; RBQ1 antibody; Retinoblastoma binding protein 6 isoform 3 antibody; Retinoblastoma binding Q protein 1 antibody; Retinoblastoma-binding protein 6 antibody; Retinoblastoma-binding Q protein 1 antibody; SNAMA antibody; SNAMA, Drosophila, homolog of antibody
-
宿主:Rabbit
-
反應種屬:Human, Mouse
-
免疫原:Recombinant Human E3 ubiquitin-protein ligase RBBP6 protein (51-97AA)
-
免疫原種屬:Homo sapiens (Human)
-
標記方式:Non-conjugated
本頁面中的產品,RBBP6 Antibody (CSB-PA768776LA01HU),的標記方式是Non-conjugated。對于RBBP6 Antibody,我們還提供其他標記。見下表:
-
克隆類型:Polyclonal
-
抗體亞型:IgG
-
純化方式:>95%, Protein G purified
-
濃度:It differs from different batches. Please contact us to confirm it.
-
保存緩沖液:Preservative: 0.03% Proclin 300
Constituents: 50% Glycerol, 0.01M PBS, pH 7.4 -
產品提供形式:Liquid
-
應用范圍:ELISA, WB, IHC, IF
-
推薦稀釋比:
Application Recommended Dilution WB 1:500-1:5000 IHC 1:20-1:200 IF 1:50-1:200 -
Protocols:
-
儲存條件:Upon receipt, store at -20°C or -80°C. Avoid repeated freeze.
-
貨期:Basically, we can dispatch the products out in 1-3 working days after receiving your orders. Delivery time maybe differs from different purchasing way or location, please kindly consult your local distributors for specific delivery time.
-
用途:For Research Use Only. Not for use in diagnostic or therapeutic procedures.
相關產品
靶點詳情
-
功能:E3 ubiquitin-protein ligase which promotes ubiquitination of YBX1, leading to its degradation by the proteasome. May play a role as a scaffold protein to promote the assembly of the p53/TP53-MDM2 complex, resulting in increase of MDM2-mediated ubiquitination and degradation of p53/TP53; may function as negative regulator of p53/TP53, leading to both apoptosis and cell growth. Regulates DNA-replication and the stability of chromosomal common fragile sites (CFSs) in a ZBTB38- and MCM10-dependent manner. Controls ZBTB38 protein stability and abundance via ubiquitination and proteasomal degradation, and ZBTB38 in turn negatively regulates the expression of MCM10 which plays an important role in DNA-replication.; (Microbial infection) restricts ebolavirus replication probably by impairing the vp30-NP interaction, and thus viral transcription.
-
基因功能參考文獻:
- RBBP6 might potentiate cervical carcinoma cell viability. PMID: 29501043
- Results from a study on gene expression variability markers in early-stage human embryos shows that RBBP6 is a putative expression variability marker for the 3-day, 8-cell embryo stage. PMID: 26288249
- RBBP6 overexpression could resist colorectal cancer cells against radiation. PMID: 29369481
- These results suggest that the RBBP6-3 isoform may be involved in promoting apoptosis in cancerous cells. PMID: 26905308
- RBBP6 is a candidate gene for myeloproliferative neoplasms (MPNs) susceptibility in a subset of pedigrees with familial MPN. PMID: 26574608
- High expression levels of RBBP6 and high apoptosis levels were found in HIV-associated nephropathy (HIVAN) cases. This direct association between RBBP6 expression and apoptosis levels suggests that RBBP6 play a role in HIVAN pathogenesis. PMID: 25910411
- gene silencing sensitises breast cancer cells to staurosporine and camptothecin-induced cell death PMID: 24703106
- RBBP6 prevents DNA damage by destabilizing the transcriptional repressor ZBTB38. PMID: 24726359
- RBBP6 gene variants are associated with glioma and contribute to glioma susceptibility PMID: 25127414
- implicate RBBP6 and iso3 as novel regulators of 3' processing, especially of RNAs with AU-rich 3' UTRs. PMID: 25319826
- these findings suggest that RBBP6 isoform 3 is a cell cycle regulator and may be deregulated in carcinogenesis PMID: 22139301
- AGO2, PACT and TRBP are required for the efficient functioning of Dicer in cells PMID: 22163034
- Taken together with the structural similarities to U-box-containing proteins, our data suggest that RBBP6 plays a role in chaperone-mediated ubiquitination and possibly in protein quality control. PMID: 22130672
- RBBP6 may be involved in the degradation of p53, thereby enhancing cell proliferation and inhibiting apoptosis in lung cancer. PMID: 21676486
- P2P-R expression may be translationally regulated by PUM2 and that P2P-R may modulate translation by influencing ribosomal protein gene expression PMID: 15617101
- RBBP6 has a role in mRNA processing and ubiquitin-like pathways PMID: 16396680
- The authors showed that RBBP6 and its isolated RING finger domain were able to ubiquitinate YB-1, resulting in its degradation in the proteosome. As a result, RBBP6 was able to suppress the levels of YB-1 in vivo and reduce its transactivational ability. PMID: 18851979
顯示更多
收起更多
-
亞細胞定位:Nucleus, nucleolus. Chromosome. Cytoplasm, cytoskeleton, microtubule organizing center, centrosome. Note=Colocalizes with mitotic chromosomes. Colocalizes with NEK6 in the centrosome.
-
組織特異性:Highly expressed in the placenta and testis. Expressed at lower levels in the brain, heart, kidney, liver and lung. Overexpressed in esophageal cancer.
-
數據庫鏈接:
Most popular with customers
-
-
YWHAB Recombinant Monoclonal Antibody
Applications: ELISA, WB, IHC, IF, FC
Species Reactivity: Human, Mouse, Rat
-
-
-
-
-
-